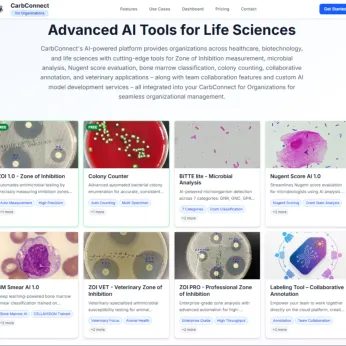

CarbGeM Inc.
Exhibitors
Information
CarbGeM Inc. is a Japan-based life science and digital health company specializing in DX and AI solutions for microbiology testing and laboratory workflows.
We develop AI-powered software, automation technologies, and cloud platforms that support image-based analysis, standardization, and efficiency improvement in microbiology laboratories. Our solutions are designed to address global challenges such as workforce shortages, variability in test quality, and the need for scalable and accessible laboratory infrastructure.
CarbGeM collaborates closely with academic institutions, hospitals, and industry partners in Japan and internationally, and has experience in regulatory-approved software as well as research-use and non-medical applications. Through technology and collaboration, we aim to enhance the quality, efficiency, and accessibility of microbiology testing worldwide.